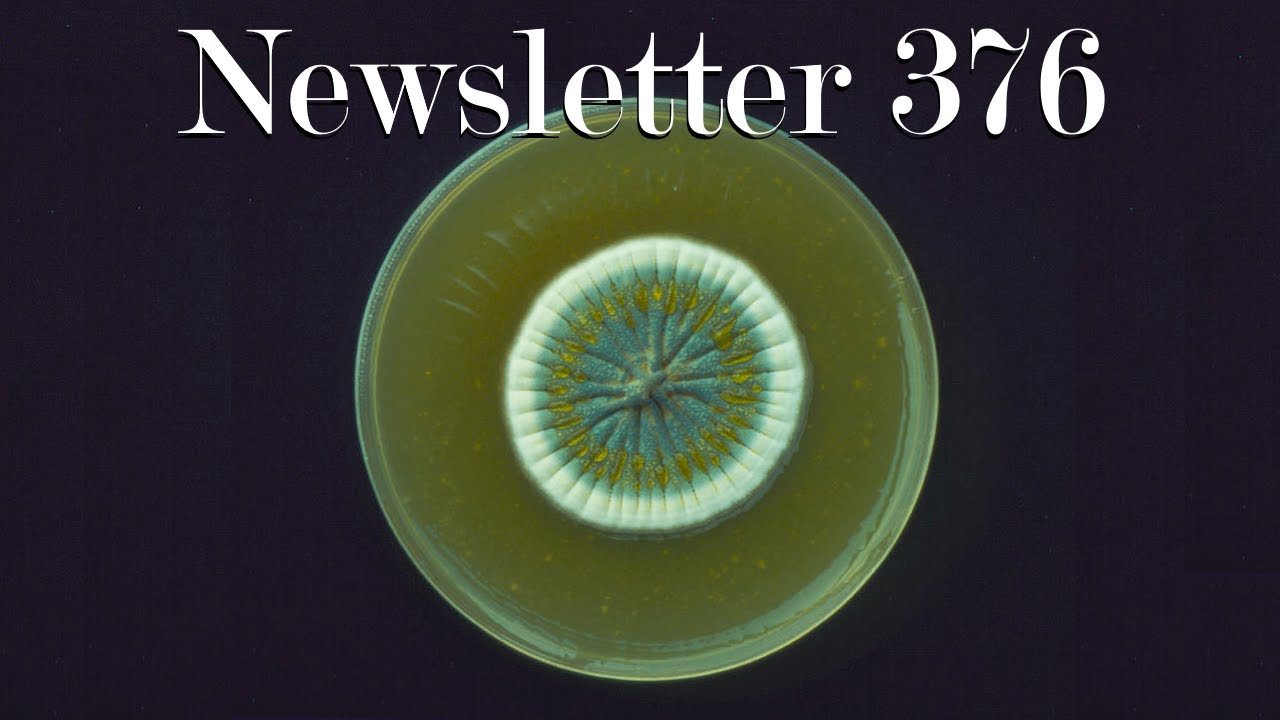
Newsletter 376: Man-Made Horrors Beyond Your Comprehension

Newsletter 376: Man-Made Horrors Beyond Your Comprehension скачать в хорошем качестве
Повторяем попытку...
Скачать видео с ютуб по ссылке или смотреть без блокировок на сайте: Newsletter 376: Man-Made Horrors Beyond Your Comprehension в качестве 4k
У нас вы можете посмотреть бесплатно Newsletter 376: Man-Made Horrors Beyond Your Comprehension или скачать в максимальном доступном качестве, видео которое было загружено на ютуб. Для загрузки выберите вариант из формы ниже:
-
Информация по загрузке:
Скачать mp3 с ютуба отдельным файлом. Бесплатный рингтон Newsletter 376: Man-Made Horrors Beyond Your Comprehension в формате MP3:
Если кнопки скачивания не
загрузились
НАЖМИТЕ ЗДЕСЬ или обновите страницу
Если возникают проблемы со скачиванием видео, пожалуйста напишите в поддержку по адресу внизу
страницы.
Спасибо за использование сервиса ClipSaver.ru
Newsletter 376: Man-Made Horrors Beyond Your Comprehension
Newsletter 376: Man-Made Horrors Beyond Your Comprehension Friday 16 January 2026 Grand Strategy Newsletter The View from Oregon – 376 Man-Made Horrors Beyond Your Comprehension https://mailchi.mp/742291a5ebcc/the-v... …in which I discuss Nikola Tesla, the Zeitgeist, when physicists knew sin, morally dubious technologies, researching consciousness, additive and subtractive engineering of the mind, brain organoids, science as a form of body horror, internalizing sacrifices for scientific knowledge, and the role suffering in the development of mind…



















